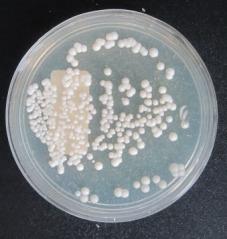
https://cdn.ncbi.nlm.nih.gov/pmc/blobs/bbde/12101135/f8f3f16176b5/HIC-20-15-g-003.jpg

外阴阴道念珠菌病的流行病学、临床及微生物学特征评估
Evaluation of epidemiological, clinical, and microbiological features of vulvovaginal candidiasis.
作者信息
Faraji Reza, Maleki Abbas, Gheisoori Abbas, Rashidi Taha, Salimi Mansouri Amirhossein, Rashidi Fatemeh, Faraji Sadegh, Kashefizadeh Alireza, Bozorgomid Arezoo
机构信息
Tuberculosis and Lung Diseases Research Center, Ilam University of Medical Sciences, Ilam, Iran.
Clinical Microbiology Research Center, Ilam University of Medical Sciences, Ilam, Iran.
出版信息
GMS Hyg Infect Control. 2025 Apr 30;20:Doc15. doi: 10.3205/dgkh000544. eCollection 2025.
BACKGROUND
Vaginal candidiasis is induced by abnormal growth of yeast on the mucous membranes of the female genital tract. Approximately 75% of women experience a yeast infection once in their lifetime. This study explored the epidemiological, clinical, and microbiological features of vaginal candidiasis in diabetic women referred to health and treatment centers in Kermanshah in 2023.
METHODS
This cross-sectional descriptive study was conducted on 215 diabetic women. A questionnaire was prepared for each participant. The samples were examined microscopically and cultured on Sabouraud dextrose agar (SDA). To identify different species of (C.), various complementary tests were performed, such as the germ tube and differential sugar absorption test (API). A sensitivity test was applied to positive samples by the broth macrodilution method. Data were analyzed using the chi-squared test in SPSS.
RESULTS
Out of the 215 vaginal swabs investigated, 66 specimens were -species positive (30.7%). 11.6% of participants were diagnosed with candidal vulvovaginitis by direct microscopic examination and 20.9% by culturing on SDA. The species isolated were: with 36 cases (54.5%), with 14 cases (21.2%), with 9 cases (13.6%) and with 7 cases (10.6%). All species isolated showed the same sensitivity to the antifungal drugs used.
CONCLUSION
The culture method was more sensitive than the direct microscopic examination. was the most prevalent species isolated from patients. Non-albicans species were not prevalent.
背景
阴道念珠菌病是由女性生殖道黏膜上酵母菌异常生长引起的。约75%的女性一生中会经历一次酵母菌感染。本研究探讨了2023年转诊至克尔曼沙赫健康与治疗中心的糖尿病女性阴道念珠菌病的流行病学、临床和微生物学特征。
方法
对215名糖尿病女性进行了这项横断面描述性研究。为每位参与者准备了一份问卷。样本进行显微镜检查,并在沙保弱葡萄糖琼脂(SDA)上培养。为鉴定不同的念珠菌属(C.)物种,进行了各种补充试验,如芽管试验和鉴别糖吸收试验(API)。通过肉汤稀释法对阳性样本进行药敏试验。使用SPSS中的卡方检验对数据进行分析。
结果
在调查的215份阴道拭子中,66份标本念珠菌属物种呈阳性(30.7%)。11.6%的参与者通过直接显微镜检查被诊断为念珠菌性外阴阴道炎,20.9%通过在SDA上培养被诊断。分离出的念珠菌属物种有:白色念珠菌36例(54.5%),光滑念珠菌14例(21.2%),热带念珠菌9例(13.6%)和近平滑念珠菌7例(10.6%)。所有分离出的物种对所用抗真菌药物表现出相同的敏感性。
结论
培养方法比直接显微镜检查更敏感。白色念珠菌是从患者中分离出的最常见物种。非白色念珠菌物种不常见。